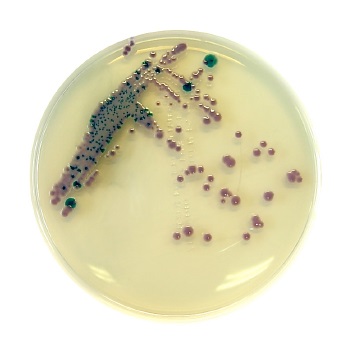

Cargando, por favor espere ...

Material para ensayos y análisis microbiológicos
| Código | Descripción | Disponibilidad | Precio 1x (€) |
Cantidad | Añadir | Precio 1x caja (€) |
Cantidad caja |
Añadir |
|---|---|---|---|---|---|---|---|---|
| 2135100876 | Chromatic™ Candida, 20 plates, Chromogenic culture media, Chromogenic selective medium for isolation and differentiation of C. albicans, C. tropicalis, C. krusei, LIOFILCHEM® | 5/12 días | 108,68 | 1 | 46,37 | 5 | ||
| 2135100881 | Chromatic Clostridium difficile, 20 plate 90 mm, Chromogenic culture media, LIOFILCHEM® | 5/12 días | 125,93 | 1 | 63,62 | 5 | ||
| 2135100882 | Chromatic™ Coliform Agar ISO, 20 plates, Chromogenic culture media, Chromogenic selective medium for E. coli and coliforms enumeration, especially suitable for waters with low bacterial count, according to ISO 9308-1:2014, LIOFILCHEM® | 5/12 días | 117,30 | 1 | 54,99 | 5 | ||
| 2135100890 | Chromatic™ Coli/Coliform, 20 plates, Chromogenic culture media, Chromogenic selective medium for E. coli and coliforms isolation and count in foods and water, LIOFILCHEM® | 5/12 días | 101,78 | 1 | 39,47 | 5 | ||
| 2135100896 | Chromatic™ Salmonella, 20 plates, Chromogenic culture media, Chromogenic selective medium for Salmonella spp. isolation and identification (including S. typhi), LIOFILCHEM® | 5/12 días | 101,78 | 1 | 39,47 | 5 | ||
| 2135100902 | Chromatic™ Detection, 20 plates, Chromogenic culture media, Chromogenic medium for urinary bacterial count and identification, LIOFILCHEM® | 5/12 días | 98,33 | 1 | 36,02 | 5 | ||
| 2135100907 | Chromatic™ Pseudomonas, 20 plates, Chromogenic culture media, Chromogenic medium for detection of Pseudomonas spp. from clinical specimens and environmental samples, LIOFILCHEM® | 5/12 días | 105,23 | 1 | 42,92 | 5 | ||
| 2135100908 | Chromatic™ Strepto B, 20 plates, Chromogenic culture media, Selective chromogenic medium for detecting Group B Streptococci (Streptococcus agalactiae), LIOFILCHEM® | 5/12 días | 122,48 | 1 | 60,17 | 5 | ||
| 2135100912 | Chromatic™ Staph aureus, 20 plates, Chromogenic culture media, Selective chromogenic medium for Staphylococcus aureus isolation, LIOFILCHEM® | 5/12 días | 108,68 | 1 | 46,37 | 5 | ||
| 2135100917 | Chromatic™ MRSA, 20 plates, Chromogenic culture media, Chromogenic medium for methicillin-resistant Staphylococcus aureus, LIOFILCHEM® | 5/12 días | 117,30 | 1 | 54,99 | 5 | ||
| 2135100921 | Chromatic™ Staph.aureus / Chromatic™ MRSA, 20 plates, Chromogenic culture media, Chromogenic media on double plate for detecting methicillin-resistant Staphylococcus aureus, LIOFILCHEM® | 5/12 días | 125,93 | 1 | 63,62 | 5 | ||
| 2135100922 | Chromatic™ CRE, 20 plates, Chromogenic culture media, Chromogenic medium for the detection of carbapenem-resistant Enterobacteriaceae directly from clinical specimens, LIOFILCHEM® | 5/12 días | 105,23 | 1 | 42,92 | 5 | ||
| 2135100926 | Chromatic™ OXA-48, 20 plates, Chromogenic culture media, Chromogenic medium for the screening of OXA-48 carbapenemase producing Enterobacteriaceae, LIOFILCHEM® | 5/12 días | 134,55 | 1 | 72,24 | 5 | ||
| 2135100927 | Chromatic™ CRE / Chromatic™ OXA-48, 20 plates, Chromogenic culture media, Chromogenic medium for the detection of carbapenem-resistant Enterobacteriaceae and screening of OXA-48 carbapenemase producing Enterobacteriaceae, LIOFILCHEM® | 5/12 días | 143,18 | 1 | 80,87 | 5 | ||
| 2135100928 | Chromatic™ ESBL, 20 plates, Chromogenic culture media, Chromogenic medium for the detection of Extended Spectrum Beta-Lactamase producing bacteria, LIOFILCHEM® | 5/12 días | 115,58 | 1 | 53,27 | 5 | ||
| 2135100929 | Chromatic™ ESBL+AmpC, 20 plates, Chromogenic culture media, Chromogenic medium for the detection of Extended Spectrum Beta-Lactamase producing bacteria, 20 cajas, LIOFILCHEM® | 5/12 días | 818,34 | 1 | Consultar | |||
| 2135100934 | Chromatic™ CRE / Chromatic™ ESBL, 20 plates, Chromogenic culture media, Chromogenic media on double plate for detecting carbapenem-resistant Enterobacteriaceae and Extended Spectrum Beta-Lactamase producing bacteria, LIOFILCHEM® | 5/12 días | 129,38 | 1 | 67,07 | 5 | ||
| 2135100935 | Chromatic™ CRE / Chromatic™ ESBL, 100 plates, Chromogenic culture media, Chromogenic media on double plate for detecting carbapenem-resistant Enterobacteriaceae and Extended Spectrum Beta-Lactamase producing bacteria, LIOFILCHEM® | 5/12 días | 281,18 | 1 | 218,87 | 5 | ||
| 2135100936 | Chromatic™ Detection / Chromatic™ ESBL, 20 plates, Chromogenic culture media, Chromogenic media on double plate for urinary bacterial count and identification and for detecting Extended Spectrum Beta-Lactamase producing bacteria, LIOFILCHEM® | 5/12 días | 119,03 | 1 | 56,72 | 5 | ||
| 2135100937 | Chromatic™ VRE, 20 plates, Chromogenic culture media, Chromogenic medium for screening Vancomycin-resistant enterococci, LIOFILCHEM® | 5/12 días | 115,58 | 1 | 53,27 | 5 | ||
| 2135100938 | Chromatic™ Bacillus cereus, 20 plates, Chromogenic culture media, Chromogenic medium for the isolation and differentiation of Bacillus cereus from food samples, LIOFILCHEM® | 5/12 días | 101,78 | 1 | 39,47 | 5 | ||
| 2135100942 | O.A. Listeria Agar, 20 plates, Chromogenic culture media, Selective chromogenic medium for Listeria monocytogenes isolation and differentiation (ISO 11290), LIOFILCHEM® | 5/12 días | 124,89 | 1 | 62,58 | 5 | ||
| 2135100947 | Chromatic™ E.coli O157, 20 plates, Chromogenic culture media, Selective chromogenic medium for detecting E. coli O157, LIOFILCHEM® | 5/12 días | 101,78 | 1 | 39,47 | 5 | ||
| 2135100951 | Chromatic™ MH, 20 plates, Chromogenic culture media, Chromogenic Mueller Hinton for presumptive identification and susceptibility testing of bacteria from clinical specimens, LIOFILCHEM® | 5/12 días | 115,58 | 1 | 53,27 | 5 | ||
| 2135100955 | Chromatic™ Vibrio, 20 plates, Chromogenic culture media, Chromogenic medium isolating and differentiating V. parahaemolyticus, V. vulnificus and V. cholerae, LIOFILCHEM® | 5/12 días | 112,13 | 1 | 49,82 | 5 | ||
| 2135100957 | TBX Agar, 20 plates, Chromogenic culture media, Selective chromogenic medium for detecting and enumerating E. coli in food according to ISO 16649, LIOFILCHEM® | 5/12 días | 92,30 | 1 | 29,99 | 5 |